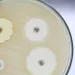

Неонатальный сепсис: антибиотикотерапия обходится микробиоте слишком дорого
Как антибиотикотерапия влияет на микробиоту кишечника новорожденных? Когда требуется применять антибиотикии и какие антибиотики наименее вредны для ребенка? Результаты рандомизированного исследования дали ответы на эти вопросы.
Раздел для широкой публики
Найдите здесь свое выделенное место
en_sources_title
en_sources_text_start en_sources_text_end
Делиться - значит заботиться
Возможно, эта тема заинтересует ваших коллег. Почему бы не поделиться ею?

Об этой статье
Колики, аллергия, ожирение, нарушение развития иммунной системы... дисбиоз кишечника у новорожденных связан с широким спектром заболеваний, которые могут сохраняться на протяжении всей жизни. Несмотря на это, антибиотики широкого спектра действия продолжают назначать неоправданно часто (их получают до 10% всех новорожденных) — как правило, из-за подозрения на ранний неонатальный сепсис (РНС).
1 из 1000
В настоящее время антибиотики назначают 4–10% всех новорожденных, тогда как инфекция подтверждается лишь у 1 из 1000 детей, означая, что > 90% детей получают ненужное им лечение.
Рандомизированное исследование трех комбинаций антибиотиков
Чтобы лучше понять влияние антибиотиков на организм детей раннего возраста было проведено рандомизированное исследование с участием 147 младенцев, получавших антибиотики широкого спектра действия на первой неделе жизни. Младенцев рандомизировали для получения одной из трех часто назначаемых внутривенных комбинаций антибиотиков: пенициллин + гентамицин, ко-амоксиклав + гентамицин или амоксициллин + цефотаксим. Контрольную группу составляли 80 здоровых младенцев, не получавших антибиотики.
Меньше разнообразие — выше резистентность
До лечения антибиотиками микробное разнообразие было одинаковым у всех младенцев, однако сразу после начала лечения происходило резкое уменьшение α-разнообразия. Впоследствии оно медленно восстанавливалось в течение первого года жизни. Также был затронут состав микробиоты кишечника. В первых образцах, собранных непосредственно после рождения, содержалось много факультативных анаэробов, таких как Escherichia и Staphylococcus, а в последующих отмечалось быстрое нарастание количества Bifidobacterium. В дальнейшем разнообразие микрофлоры зависело от статуса антибиотикотерапии. В микробиоте леченных детей было меньше Bifidobacterium spp., Escherichia, Staphylococcus spp., Bacteroides и больше — Klebsiella и Enterococcus spp. Наконец, в микрофлоре детей, получавших антибиотики, обнаружили больше генов резистентности к противомикробным препаратам.
более 90% младенцев с подозрением на РНС назначают антибиотики, даже если диагноз точно не подтвержден.
Не все антибиотики одинаковы
Отмечены значимые различия между тремя режимами антибиотиков: сильнее всего на состав микробиоты кишечника и резистентность к противомикробным препаратам влияла комбинация амоксициллин + цефотаксим, а наименьшим влиянием обладала комбинация пенициллин + гентамицин. Исследователи рекомендуют обратить на последнюю комбинацию более пристальное внимание и чаще применять ее у новорожденных.
В каждом случае эффекты антибиотикотерапии были более выраженными и продолжительными, чем ожидалось, вероятно, потому что микробиота младенцев еще находится в процессе развития (в то время как предыдущие исследования были сосредоточены на детях старшего возраста). В настоящее время более 90% младенцев с подозрением на РНС назначают антибиотики, даже если диагноз точно не подтвержден. По мнению авторов, это подчеркивает важность повышения точности диагностики РНС, так как серьезные последствия антибиотикотерапии могут сохраняться долгое время.
Читайте также